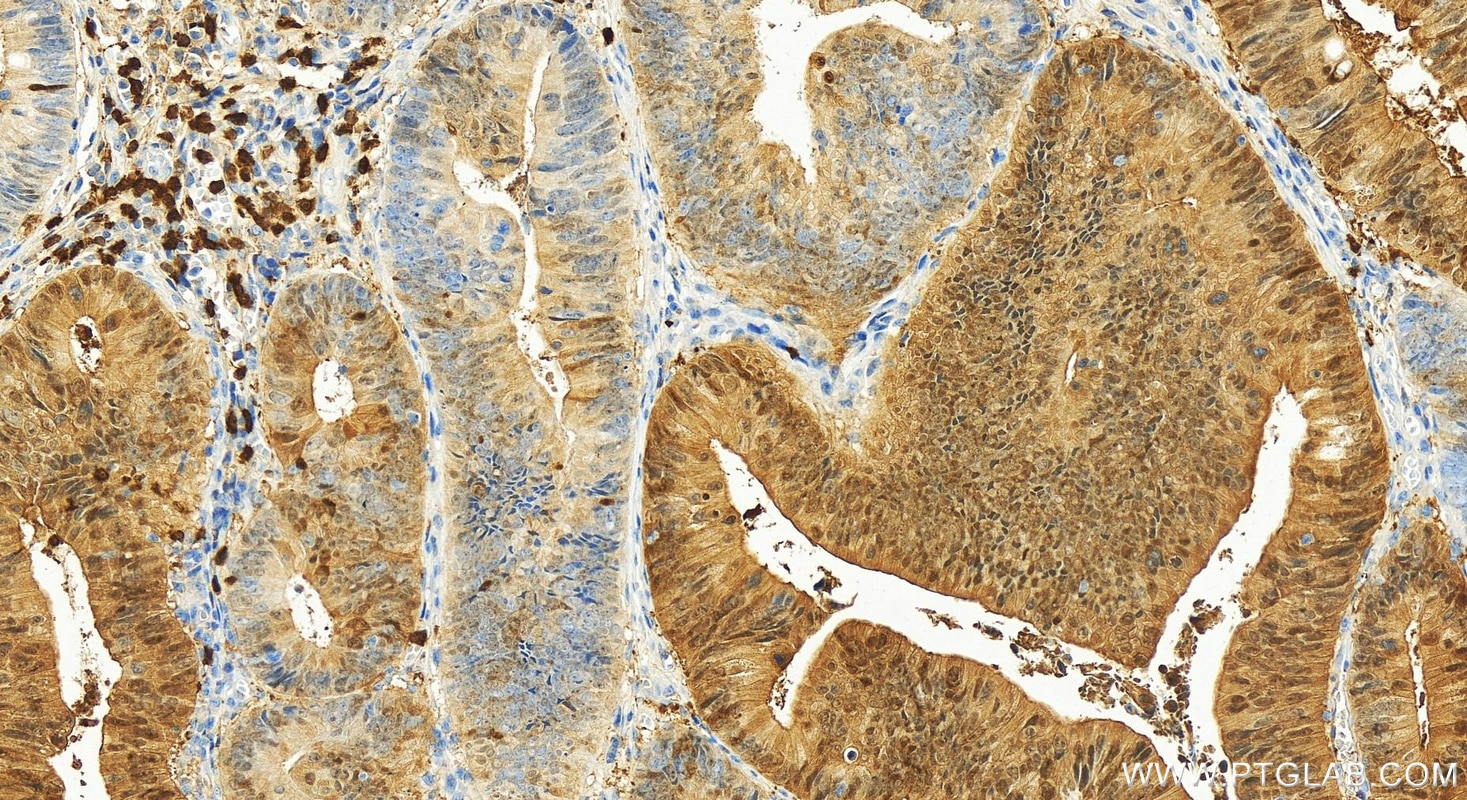
Immunohistochemical analysis of paraffin-embedded human colon cancer tissue slide using 11803-1-AP (S100P antibody) at dilution of 1:1200 (under 20x lens). Heat mediated antigen retrieval with Tris-EDTA buffer (pH 9.0). Immunohistochemistry (IHC) staining of human colon cancer tissue using S100P Polyclonal antibody (11803-1-AP)

Tested Applications
| Positive WB detected in | HeLa cells, HuH-7 cells |
| Positive IHC detected in | human pancreas cancer tissue, human bowen disease tissue, human colon cancer tissue, human urothelial carcinoma tissue Note: suggested antigen retrieval with TE buffer pH 9.0; (*) Alternatively, antigen retrieval may be performed with citrate buffer pH 6.0 |
| Positive IF/ICC detected in | HeLa cells |
Recommended dilution
| Application | Dilution |
|---|---|
| Western Blot (WB) | WB : 1:500-1:2000 |
| Immunohistochemistry (IHC) | IHC : 1:200-1:6000 |
| Immunofluorescence (IF)/ICC | IF/ICC : 1:200-1:800 |
| It is recommended that this reagent should be titrated in each testing system to obtain optimal results. | |
| Sample-dependent, Check data in validation data gallery. | |
Published Applications
| WB | See 4 publications below |
| IHC | See 7 publications below |
Product Information
11803-1-AP targets S100P in WB, IHC, IF/ICC, ELISA applications and shows reactivity with human samples.
| Tested Reactivity | human |
| Cited Reactivity | human, mouse |
| Host / Isotype | Rabbit / IgG |
| Class | Polyclonal |
| Type | Antibody |
| Immunogen |
CatNo: Ag2379 Product name: Recombinant human S100P protein Source: e coli.-derived, PGEX-4T Tag: GST Domain: 1-95 aa of BC006819 Sequence: MTELETAMGMIIDVFSRYSGSEGSTQTLTKGELKVLMEKELPGFLQSGKDKDAVDKLLKDLDANGDAQVDFSEFIVFVAAITSACHKYFEKAGLK Predict reactive species |
| Full Name | S100 calcium binding protein P |
| Calculated Molecular Weight | 95 aa, 11 kDa |
| Observed Molecular Weight | 10 kDa |
| GenBank Accession Number | BC006819 |
| Gene Symbol | S100P |
| Gene ID (NCBI) | 6286 |
| RRID | AB_2184577 |
| Conjugate | Unconjugated |
| Form | Liquid |
| Purification Method | Antigen affinity purification |
| UNIPROT ID | P25815 |
| Storage Buffer | PBS with 0.02% sodium azide and 50% glycerol, pH 7.3. |
| Storage Conditions | Store at -20°C. Stable for one year after shipment. Aliquoting is unnecessary for -20oC storage. 20ul sizes contain 0.1% BSA. |
Background Information
S100P protein is a relatively small (95 amino acid) isoform of the S100 protein family that was first isolated from human placenta. Overexpression of S100P has been detected in several cancers such as breast, colon, prostate, pancreatic and lung carcinomas, and the protein has been functionally implicated in carcinogenic processes. S100P protein is widely expressed in both normal and neoplastic tissues. It clearly shows ectopic expression in some cancers. Based on the high expression in certain tumors, S100P could represent a potential target for novel diagnostic and therapeutic applications.
Protocols
| Product Specific Protocols | |
|---|---|
| IF protocol for S100P antibody 11803-1-AP | Download protocol |
| IHC protocol for S100P antibody 11803-1-AP | Download protocol |
| WB protocol for S100P antibody 11803-1-AP | Download protocol |
| Standard Protocols | |
|---|---|
| Click here to view our Standard Protocols |
Publications
| Species | Application | Title |
|---|---|---|
Adv Sci (Weinh) RBMS1 Coordinates with the m6 A Reader YTHDF1 to Promote NSCLC Metastasis through Stimulating S100P Translation | ||
Cancer Lett Liver metastasis or peritoneal metastasis: single-cell RNA sequencing reveals the organotropism in colorectal cancer is driven by distinct partial-EMT processes | ||
Am J Cancer Res High expression of S100P is associated with unfavorable prognosis and tumor progression in patients with epithelial ovarian cancer. | ||
Proteomics Clin Appl Identification of distinctive protein expression patterns in colorectal adenoma. | ||
Diagn Pathol Basal cell adenocarcinoma of the salivary gland: a morphological and immunohistochemical comparison with basal cell adenoma with and without capsular invasion. | ||
Exp Ther Med Proof-of-concept study investigating the role of S100P-RAGE in nasopharyngeal carcinoma. |